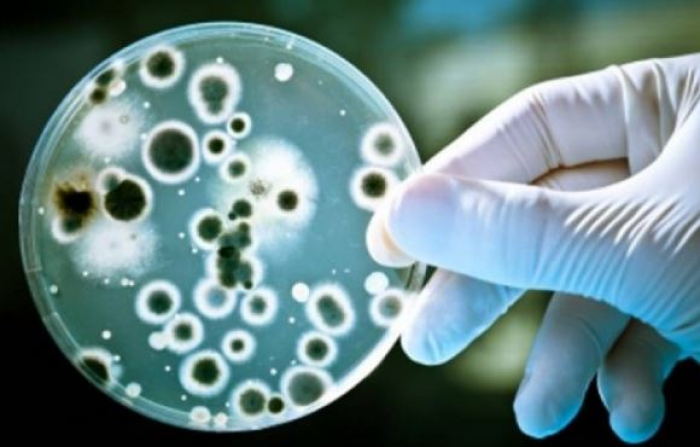

Студија: Микроорганизмите во телото на човекот влијаат врз тежината на ковид симптомите
Кинеските научници од Универзитетот во Хонг Конг објавија дека некои микроорганизми во системот за варање влијаат на одговорот на имунолошкиот систем на човекот и на тежината на болеста кај заразените лица со Ковид-19.
– Познато е дека заболените од Ковид-19 во својот гастро-интестинален тракт немаат некои добри бактерии, кои се познати како регулатори и стимулатори на човечкиот имунолошки систем, тврди д-р Сију Бг од Кинескиот Универзитет во Хонг Конг.
Таа во студијата објавена во научното списание „Гут“ наведува дека „дисбиос“ односно некои абнормални бактерии во нашиот систем за варање остануваат и по зазравувањето од Ковид-19 и влијаае врз развој на долгорочни стомачни заболувања.
Ново на Сител
-

Новиот најмал електричен автомобил „смарт“ пристигнува во септември | ВИДЕО
-

Над 70 проценти раст во авиосообраќајот во последните 2 години
-

Хегсет: Американската војска треба да добие Нобелова награда за мир
-

Уапсен 29-годишен гостиварчанец, силувал малолетничка и објавил експлицитни содржини од неа
-

Од ССКМ бараат транспарентна истрага и нулта толеранција за нелегални медицински практики
-

Иранскиот министер за надворешни работи Арагчи се сретна со пакистански претставници во Исламабад
-

Поднесена кривична пријава за бесправно градење и узурпација на недвижности во Кочани
-

Две лица, меѓу нив судски полицаец, под истрага за примање награда за противзаконито влијание



